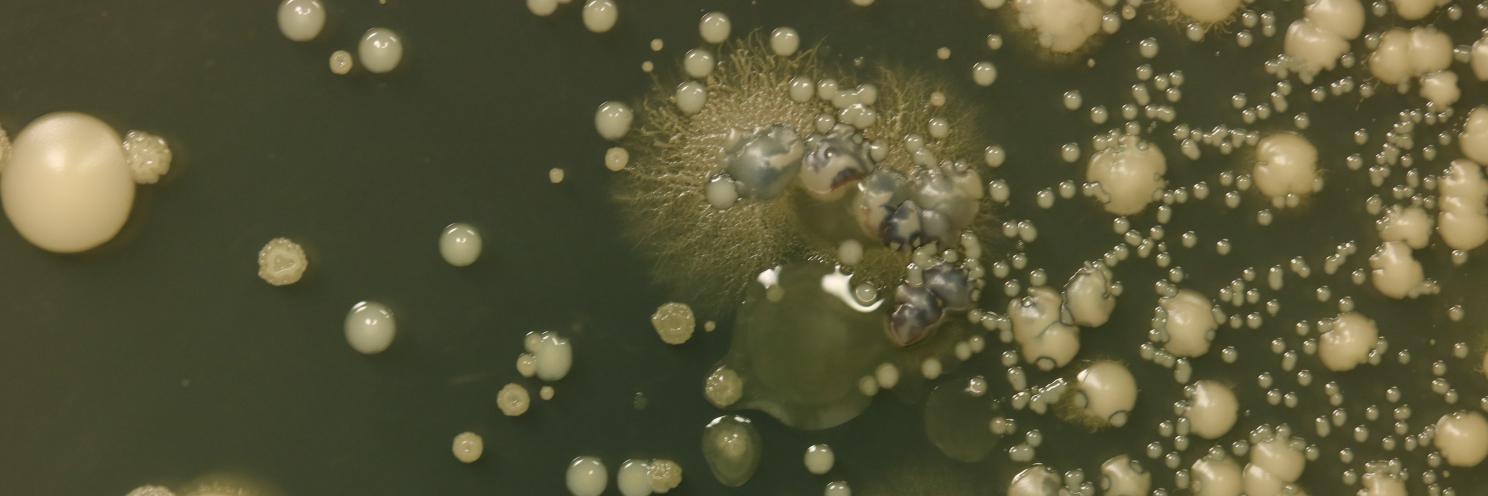
dinosaur banner

Delighted to share the latest publication from the Hogan Lab by Dallas Mould and Nico Botelho. Check out how interactions between recently diverged genotypes can lead to increased virulence-associated properties! mbio.asm.org/content/11/4/e…
dinosaur
25 posts

Delighted to share the latest publication from the Hogan Lab by Dallas Mould and Nico Botelho. Check out how interactions between recently diverged genotypes can lead to increased virulence-associated properties! mbio.asm.org/content/11/4/e…

A predictive model of gene expression reveals the role of regulatory motifs in the mating response of yeast biorxiv.org/cgi/content/sh… #biorxiv_sysbio






#MicroRounds day 65: Back in time for #FungalFriday! Exophiala are black yeasts that produce "moniliform hyphae." Colonies are wet and slimy initially but become velvety/leathery with age. The plate below is 3 weeks old. #ASMClinMicro #medtwitter #IDpath


Pseudomonas aeruginosa lasR mutant fitness in microoxia is supported by an Anr-regulated oxygen-binding hemerythrin biorxiv.org/cgi/content/sh… #bioRxiv

